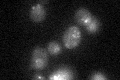

View description
Silencing protein that interacts with Sir2p and Sir4p, and histone H3 and H4 tails, to establish a transcriptionally silent chromatin state; required for spreading of silenced chromatin; recruited to chromatin through interaction with Rap1p
Localization:
Intensity:
Fold change:
Significance:
-
C’ GFP library in SD
nuclear periphery20.09 -
N' NOP1pr-GFP in SD

nucleus,nucleolus65.4641 -
N' TEF2pr-mCherry in SD

nucleus55.2798 -
N' NATIVEpr-GFP in SD

punctate,nuclear periphery28.11 -
N' TEF2pr-VC and Cyto-VN in SD

#N/A0 -
C’ GFP library in SD+DTT

nuclear periphery22.591.12No -
C’ GFP library in SD+H2O2

nuclear periphery20.931.04No -
C’ GFP library in Starvation Media

nuclear periphery22.11.09No -
C’ GFP library on the background of Pup2-DaMP

nuclear periphery -
C’ GFP library on the background of CCT mutant

nuclear periphery21.86391.0877No
